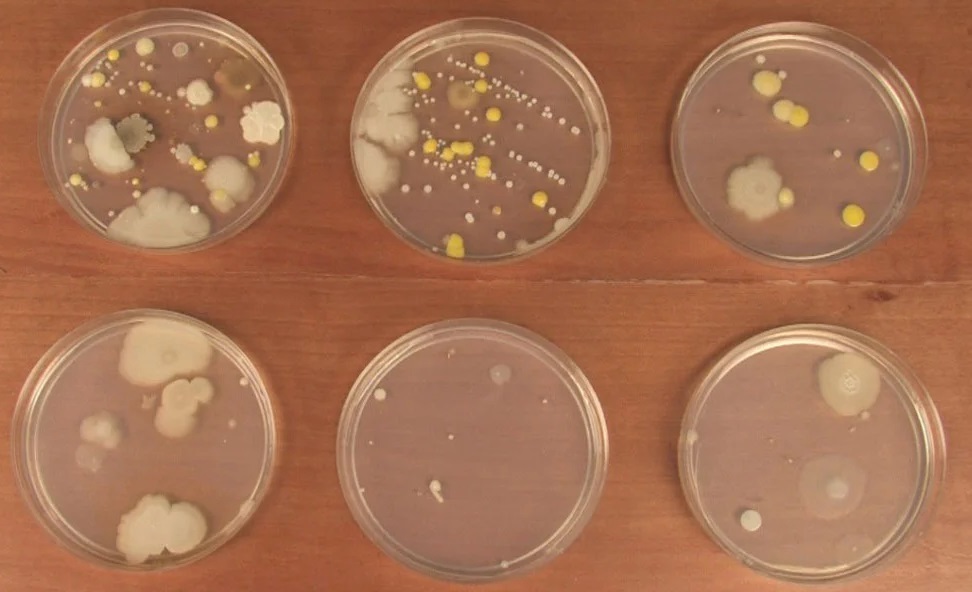

BACTERIA
Bacteria are microbes with a cell structure simpler than that of many other organisms. Their their control center, containing the genetic information, is contained in a single loop of DNA. Some bacteria have an extra circle of genetic material called a plasmid rather than a nucleus. The plasmid often contains genes that give the bacterium some advantage over other bacteria. For example it may contain a gene that makes the bacterium resistant to a certain antibiotic.
Bacteria are classified into five groups according to their basic shapes: spherical (cocci), rod (bacilli), spiral (spirilla), comma (vibrios) or corkscrew (spirochaetes). They can exist as single cells, in pairs, chains or clusters.

Bacteria are found in every habitat on Earth: soil, rock, oceans and even arctic snow. Some live in or on other organisms including plants and animals including humans. There are approximately 10 times as many bacterial cells as human cells in the human body. A lot of these bacterial cells are found lining the digestive system. Some bacteria live in the soil or on dead plant matter where they play an important role in the cycling of nutrients. Some types cause food spoilage and crop damage but others are incredibly useful in the production of fermented foods such as yoghurt and soy sauce. Relatively few bacteria are parasites or pathogens that cause disease in animals and plants.

How do bacteria reproduce?
Most bacteria reproduce by binary fission. In this process the bacterium, which is a single cell, divides into two identical daughter cells. Binary fission begins when the DNA of the bacterium divides into two (replicates). The bacterial cell then elongates and splits into two daughter cells each with identical DNA to the parent cell. Each daughter cell is a clone of the parent cell.
When conditions are favourable such as the right temperature and nutrients are available, some bacteria like Escherichia coli can divide every 20 minutes. This means that in just seven hours one bacterium can generate 2,097,152 bacteria. After one more hour the number of bacteria will have risen to a colossal 16,777,216. That’s why we can quickly become ill when pathogenic microbes invade our bodies.
Survival mechanism
Some bacteria can form endospores. These are dormant structures, which are extremely resistant to hostile physical and chemical conditions such as heat, UV radiation and disinfectants. This makes destroying them very difficult. Many endospore-producing bacteria are nasty pathogens, for example Bacillus anthracis, the cause of anthrax.
OBSERVING BACTERIA IN A PETRI DISH
Students should examine cultures in containers, which have been taped and closed. Colony morphology is a method that scientists use to describe the characteristics of an individual colony of bacteria growing on agar in a Petri dish. It can be used to help to identify them.


Colonies differ in their shape, size, colour and texture. Can you count how many different colony types there are? Use the diagrams on colony morphology to help you interpret your plate.

Colonies differ in their shape, size, colour and texture. Can you count how many different colony types there are? Use the diagrams on colony morphology to help you interpret your plate


Different types of bacteria will produce different-looking colonies, some colonies may be coloured, some colonies are circular in shape, and others are irregular. A specific terminology is used to describe common colony types. These are:
- Form – what is the basic shape of the colony? For example, circular, filamentous, etc.
- Size – the diameter of the colony. Tiny colonies are referred to as punctiform.
- Elevation – this describes the side view of a colony. Turn the Petri dish on end.
- Margin/border – the edge of a colony. What is the magnified shape of the edge of the colony?
- Surface – how does the surface of the colony appear? For example, smooth, glistening, rough, wrinkled or dull.
- Opacity – for example, transparent (clear), opaque, translucent (like looking through frosted glass), etc.
- Colour (pigmentation) – for example, white, buff, red, purple, etc.
Each distinct colony represents an individual bacterial cell or group that has divided repeatedly. Being kept in one place, the resulting cells have accumulated to form a visible patch. Most bacterial colonies appear white or a creamy yellow in colour, and are fairly circular in shape.
To grow bacteria on an agar plate.
Requirement :
- Nutrient Agar ,
- Distilled Water,
- Sample bottle with screw cap,
- Petri dish disposable,
- Dry cotton swab disposable.
Safety first, wear Lab coat, Goggle & Disposable Glove.
Take Nutrient Agar 50 gm in
Sample Bottle screw cap HDPE bottle or glass heat resistance bottle for Mixing 125ml solution
Heat mixture in Microwave, 1 minute, mix if well by shaking bottle slowly till powder dissolve.
Open the lid of a petri dish just enough to pour some liquid agar in tilt the dish until the agar covers the whole dish. Then let it sit for an hour so the agar. Solidifies.
now your Agar plate is ready to proceed for bacteria culture
Collect bacteria in Swab from Different surface you want to test bacteria possibility.
Rub Swab slowly on gel in Z shape writing on gel nutrient agar in petri dish.
Label of each sample Petri dish and leave each sample 3 to 7 days in dark , Room temperature to group bacteria in petri dish.
Link to Video how to create Bacterial Culture plate by Nutrient Agar
link to Video How to Prepared bacteria Culture
Above data given for School Teacher guidence.
by M. Adeel.